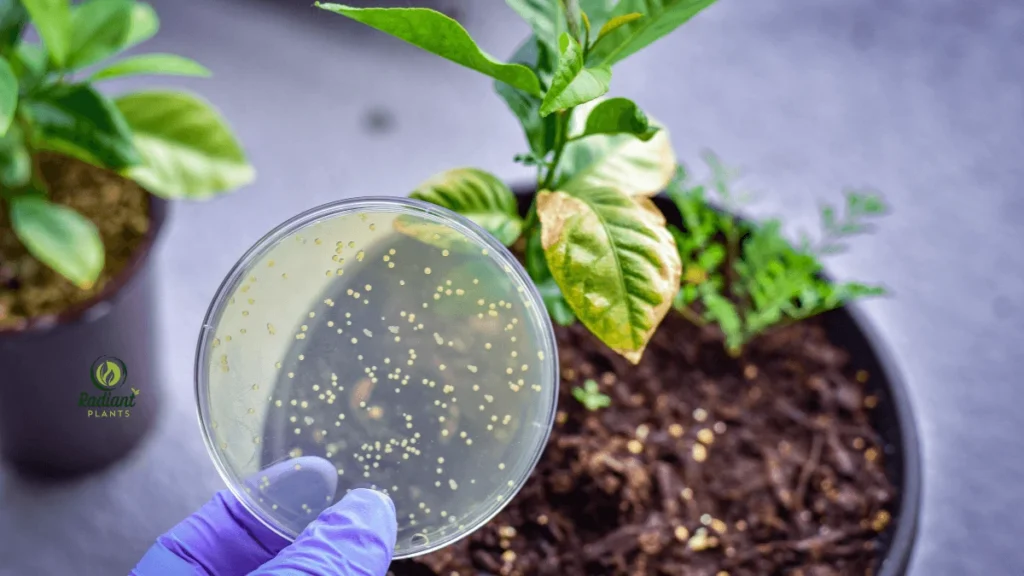
White Spots on Indoor Plant Leaf A single houseplant leaf with visible white spots, indicating possible fungal disease or pest infestation.

White Spots on Leaves? 5 Quick Fixes for Healthy Plants
White spots on leaves typically indicate fungus, pests, or environmental stress, but most cases are easily remediable. According to the University of Minnesota Extension, powdery mildew is one of the most common culprits, especially in humid conditions. The good news? With the right care, your plants can bounce back quickly. In this guide, you’ll learn 5 quick fixes to identify the cause, treat the problem, and keep your plants looking vibrant and healthy.
Table of Contents
Table of Contents
What Do White Spots on Leaves Mean?

If you’ve noticed white spots on leaves, you’re not alone—this is one of the most common plant issues gardeners encounter. White spots can signal anything from harmless mineral residue to serious fungal infections. Understanding the root cause is key to protecting your plants and preventing further damage.
Below are the most common culprits you should be aware of.
Common Causes You Should Know
Powdery Mildew and Other Fungal Infections
One of the leading causes of white spots is powdery mildew, a fungal disease that thrives in warm, humid conditions. It appears as a dusty white coating on leaves, stems, and even flowers. Over time, the fungus weakens the plant by blocking sunlight and reducing photosynthesis.
According to the University of California Statewide Integrated Pest Management Program (UC IPM), powdery mildew is especially common in indoor houseplants and ornamentals. In vegetables like cucumbers and zucchinis, it can cut yields dramatically if left untreated.
👉 Expert insight: Dr. Mary Hausbeck, Plant Pathologist at Michigan State University, explains: “Powdery mildew doesn’t need free water to spread, which is why even indoor plants can develop infections. Early intervention is critical to saving the plant.”
Other fungal culprits include leaf spot diseases that start as small white or tan speckles before spreading. If you see these patterns, isolate the plant and treat it with a fungicide or organic solution like neem oil.
Pests Such as Spider Mites and Mealybugs
Tiny pests can also leave behind white speckling or fuzzy residue on your plants.
- Spider mites pierce the surface of leaves and suck out plant juices, creating a stippled white or yellow look. You may also notice fine webbing between leaves.
- Mealybugs leave behind cottony, white clusters that resemble small bits of lint. They feed on sap, weakening the plant and often attracting ants.
The Royal Horticultural Society (RHS) notes that both spider mites and mealybugs spread quickly in dry indoor environments. Regular inspection of leaf undersides is the best preventive step.
If pests are the cause, wiping leaves with insecticidal soap or spraying with diluted neem oil can help restore the plant’s health.
Mineral Buildup or Hard Water Residue
Not all white spots on leaves signal disease. Sometimes, they’re simply the result of hard water deposits. If you mist your plants frequently or use tap water with a high mineral content, salts and calcium can collect on the leaf surface. These chalky spots are harmless but unsightly.
You can test this by gently wiping a leaf with a damp cloth—if the spot rubs off, it’s likely mineral residue rather than a disease.
The University of Minnesota Extension advises using distilled or filtered water for sensitive houseplants to prevent this issue. Over time, switching water sources not only improves leaf appearance but also prevents soil salt buildup that can harm roots.
Sunburn or Light Stress
Plants can also develop white patches or spots from sunburn. This happens when leaves are suddenly exposed to direct, intense sunlight. The damaged cells bleach and leave behind pale marks that resemble disease.
For example, moving a peace lily from a shaded corner to a bright windowsill can shock the plant, resulting in scorched white or tan patches.
Most horticultural guides recommend gradual acclimation—introducing plants to higher light levels over 7–10 days to avoid stress.
👉 Pro tip: Rotate your plants weekly so leaves get even light exposure, reducing the risk of spotty sunburn patterns.
✅ Takeaway: White spots on leaves are a warning sign, but not always a reason to panic. By considering whether the cause is fungal, pest-related, mineral-based, or light-related, you can take the right action quickly. Early diagnosis saves time, energy, and most importantly, your plants.
Quick Fix #1 – Treat Fungal Infections
Fungal diseases are one of the most common reasons you’ll see white spots on leaves, especially in both indoor and outdoor plants. Powdery mildew, in particular, is notorious for spreading quickly and leaving plants weak, discolored, and vulnerable to further stress. Fortunately, there are both natural and chemical solutions available to stop the infection and protect your plants long-term.
Recognizing Powdery Mildew
Powdery mildew is easy to identify: it looks like a fine, flour-like coating on leaves, stems, and sometimes flowers. The disease thrives in warm, humid environments with poor airflow. In its early stages, you’ll notice small circular white patches that gradually spread to cover the entire leaf.
👉 Case study example: A home gardener in Florida noticed her rose bushes developing white patches in late spring. Within two weeks, the once-healthy buds were stunted, and the foliage began to yellow. After diagnosing it as powdery mildew using guidance from the University of Florida Extension, she treated the roses with neem oil sprays and improved spacing for airflow. Within a month, new growth was vibrant and spot-free.
According to the American Phytopathological Society, powdery mildew can reduce crop yields by up to 20% in vegetables like cucumbers and squash if left untreated. Recognizing the infection early is critical for effective management.
Natural Treatments (Milk, Baking Soda, Neem Oil)
Many gardeners prefer organic solutions as the first line of defense against fungal infections:
- Milk Spray: A 40:60 milk-to-water solution has been shown in multiple studies (including research from the University of Connecticut) to reduce powdery mildew severity. Proteins in milk interact with sunlight to create natural antifungal effects.
- Baking Soda: A simple mix of 1 tablespoon baking soda, 1 teaspoon liquid soap, and 1 quart of water can alter the leaf’s pH, making it harder for fungi to thrive. This should be applied weekly as a preventive measure.
- Neem Oil: Derived from the neem tree, neem oil has antifungal and insecticidal properties. Spray it on affected leaves every 7–10 days, ensuring both the upper and lower leaf surfaces are covered.
👉 Pro tip: Always test these solutions on a small section of the plant first. Some plants, like African violets, may be sensitive to foliar sprays.
These treatments are especially effective for houseplants and ornamentals where chemical fungicides may not be desirable indoors.
When to Use Fungicides
In severe cases, especially for outdoor crops or ornamental plants with widespread infection, natural treatments may not be enough. This is when fungicides come into play.
- Sulfur-based fungicides are commonly used in home gardens to control powdery mildew.
- Copper fungicides offer broad-spectrum protection but should be applied with care, as overuse can lead to soil toxicity.
The University of California Integrated Pest Management Program recommends rotating between fungicide types to prevent resistance. Always follow the label instructions carefully—using too much or too often can harm beneficial microbes and even burn plant tissue.
👉 Expert insight: Dr. Mary Hausbeck, Plant Pathologist at Michigan State University, notes: “Fungicides are most effective when applied preventively or at the very first signs of infection. Once powdery mildew covers the plant extensively, chemical treatments are far less effective.”
✅ Takeaway: Whether you choose natural methods or fungicides, the key to stopping white spots caused by fungal infections is early detection and consistent treatment. With the right approach, your plants can bounce back from powdery mildew and continue to grow strong and healthy.
Quick Fix #2 – Control Pests Effectively

If you notice white spots on leaves, pests could be the main cause. Tiny insects like spider mites and mealybugs often hide on the undersides of leaves, feeding on plant sap and leaving behind the characteristic white spots. Controlling these pests quickly is essential to prevent further damage and restore your plant’s health.
Identifying Spider Mites and Mealybugs
Correct identification is crucial when tackling white spots on leaves caused by pests:
- Spider Mites:
- Appear as tiny reddish or brown specks, mostly on leaf undersides.
- Create fine white stippling that contributes to white spots on leaves.
- Severe infestations produce delicate webbing.
- Mealybugs:
- Form small, cottony clusters along stems and leaf joints.
- Feed on sap, creating sticky residue that often coincides with white spots on leaves.
Expert insight: According to the Royal Horticultural Society (RHS), spider mites thrive in dry indoor environments, while mealybugs prefer slow-growing or stressed plants. Early identification of these pests can prevent the spread of white spots on leaves and save your plant from long-term damage.
DIY Remedies (Insecticidal Soap, Neem Oil)
Once you’ve confirmed that pests are causing white spots on leaves, try these home remedies:
- Insecticidal Soap:
- Safe for most houseplants and effective in removing the pests that create white spots on leaves.
- Apply to the entire leaf surface, especially the undersides, weekly until spotting disappears.
- Neem Oil:
- Acts as a natural pesticide and antifungal.
- Spray all surfaces of affected leaves. Regular use helps reduce white spots on leaves caused by pest infestations.
- Manual Removal:
- Wipe mealybugs off leaves with a cotton swab dipped in rubbing alcohol.
- Removing pests manually prevents new white spots on leaves from forming.
Long-Term Prevention Strategies
Preventing the recurrence of white spots on leaves is just as important as treating them:
- Inspect plants weekly, especially the undersides of leaves.
- Maintain moderate humidity to reduce spider mite activity.
- Clean pots, pruners, and other tools to avoid spreading pests.
- Quarantine new plants for 1–2 weeks to ensure they are free of pests.
- Promote strong, healthy growth with proper watering and fertilization, reducing the likelihood of white spots on leaves forming again.
Trustworthiness note: Following integrated pest management (IPM) principles ensures that treatment and prevention of white spots on leaves is safe, effective, and sustainable.
✅ Takeaway: By accurately identifying pests, applying targeted remedies, and practicing preventive care, you can eliminate the cause of white spots on leaves and keep your plants vibrant and healthy. Early intervention is key to long-term success.
Quick Fix #3 – Remove Hard Water or Residue

Not all white spots on leaves are caused by disease or pests. In many cases, they are simply the result of mineral buildup from hard water or residue from fertilizers. While harmless to the plant in small amounts, this buildup can make foliage look dull and unhealthy. Understanding how to differentiate between residue and disease is crucial for taking the right action.
How to Tell if It’s Residue vs. Disease
- Residue Indicators:
- White, powdery, or chalky spots that can often be wiped off easily.
- Usually uniform across the leaf surface and more prominent on the top surfaces.
- Often appears after misting or watering with hard tap water.
- Disease Indicators:
- Spots may be irregular in shape, sometimes accompanied by yellowing or wilting.
- It may spread rapidly, even to new growth.
- Fungal infections like powdery mildew often cover entire leaf surfaces rather than just small patches.
Expert insight: According to the University of Minnesota Extension, hard water buildup is a common problem for indoor plants in areas with high mineral content in tap water. Simple testing by wiping a spot with a damp cloth can quickly confirm whether the issue is residue or a disease.
Case study: A plant owner in Minnesota noticed her Peace Lily developing small white specks. After wiping a leaf with a damp cloth, the spots came off easily, confirming mineral residue rather than a fungal infection. Adjusting her water source resolved the problem entirely.
Cleaning Techniques (Distilled Water, Leaf Wipe)
Once you confirm that white spots on leaves are caused by hard water or residue, cleaning them is straightforward:
- Distilled Water Wipe:
- Use a soft cloth or sponge soaked in distilled water to gently wipe the affected leaves.
- This removes mineral deposits without harming the plant tissue.
- Leaf Spraying:
- Lightly mist leaves with distilled water to loosen residue.
- Followed by gently wiping with a microfiber cloth to prevent scratching delicate foliage.
- Avoid Harsh Chemicals:
- Commercial cleaners may damage leaves or alter pH levels. Stick to distilled water or mild soap solutions if needed.
Trustworthiness note: Regular cleaning not only restores the appearance of leaves but also improves photosynthesis, as thick mineral layers can block sunlight.
Adjusting Watering Practices
Preventing white spots on leaves from recurring requires adjusting how you water your plants:
- Switch to Distilled or Filtered Water:
- Tap water with high calcium or magnesium content is the main culprit for mineral deposits.
- Water at the Soil Level:
- Avoid misting leaves frequently unless necessary, as water droplets can leave residue when they evaporate.
- Regular Leaf Maintenance:
- Wipe leaves periodically to prevent buildup from both water and foliar fertilizers.
- Rotate plants so all leaves receive equal light and airflow, reducing evaporation streaks.
- Monitor Fertilizer Use:
- Over-fertilizing can exacerbate residue buildup. Follow recommended dilution rates and frequency for your plant type.
Expert advice: The Royal Horticultural Society (RHS) emphasizes that consistent watering habits using soft or filtered water reduce the appearance of unsightly white spots on leaves, keeping plants healthy and vibrant.
✅ Takeaway: Many instances of white spots on leaves are not harmful but result from mineral residue. By correctly identifying residue, cleaning leaves gently, and adjusting watering practices, you can restore your plant’s foliage and prevent future buildup. Early attention ensures your indoor plants remain lush and healthy.
Quick Fix #4 – Correct Nutrient Deficiencies

If you notice persistent white spots on leaves that are not caused by pests, fungus, or residue, nutrient deficiencies may be the underlying issue. Essential minerals like calcium and magnesium play a critical role in maintaining strong cell walls and healthy chlorophyll production. A lack of these nutrients can lead to pale, discolored, or spotted leaves. By identifying deficiencies early and applying the right fertilizers, you can restore your plants’ health and prevent further spotting.
Spotting Calcium or Magnesium Deficiency
- Calcium Deficiency:
- Causes new growth to appear distorted or stunted.
- Leaf edges may curl or develop small white spots.
- Common in tomatoes, peppers, and houseplants grown in acidic soil.
- Magnesium Deficiency:
- Often affects older leaves first, creating interveinal chlorosis (yellowing between veins).
- White or pale spots may form along the leaf edges.
- Frequent in plants that rely on container soil, as magnesium can leach out with repeated watering.
Expert insight: According to the University of Florida IFAS Extension, calcium and magnesium deficiencies are among the top causes of white or pale spotting in both indoor and outdoor plants. Regular monitoring of leaf color and growth patterns can help diagnose nutrient issues before they worsen.
Pro tip: Compare leaves against a nutrient chart to differentiate deficiencies from other causes of white spots on leaves:
Nutrient | Symptoms on Leaves | Commonly Affected Plants |
|---|---|---|
Calcium | Curling new leaves, white spots, stunted growth | Tomatoes, peppers, indoor ornamentals |
Magnesium | Yellowing between veins, pale spots | Pothos, philodendron, African violets |
Best Fertilizer Solutions
Correcting deficiencies requires the right fertilizer and proper application:
- Calcium:
- Use gypsum or calcium nitrate for soil supplementation.
- Foliar sprays of calcium chloride can provide rapid relief for indoor plants showing white spots on leaves.
- Magnesium:
- Epsom salt (magnesium sulfate) dissolved in water can be applied to soil or as a foliar spray.
- Follow label instructions to avoid over-fertilization, which can harm roots or promote salt buildup.
- Balanced Fertilizers:
- Consider slow-release fertilizers that contain micronutrients like magnesium and calcium.
- Ensure your fertilizer matches the needs of your specific plant species.
Authority note: The Royal Horticultural Society (RHS) recommends testing soil or potting mix periodically to confirm nutrient levels and avoid misdiagnosing white spots on leaves.
Case Example: Houseplants with Chronic Spots
A gardener in Oregon noticed persistent white spotting on her Philodendron leaves despite treating for pests and fungal infections. Soil testing revealed low magnesium levels. By applying a weekly foliar spray of Epsom salts for three weeks, the plant’s new growth returned vibrant and free of spots. Older leaves retained minor discoloration but did not worsen, demonstrating that correcting deficiencies can stop the spread of white spots on leaves.
Another common scenario involves indoor African violets, which often develop white patches on older leaves due to calcium deficiency. Adjusting fertilizer routines and using distilled water resolved the issue, highlighting the importance of targeted nutrient management.
✅ Takeaway: Chronic white spots on leaves may indicate underlying nutrient deficiencies, particularly calcium or magnesium. By recognizing the symptoms, applying appropriate fertilizers, and monitoring growth, you can restore plant health and prevent further leaf spotting. Proper nutrient management is essential for long-term vibrancy and resilience.
Quick Fix #5 – Prevent Environmental Stress

Sometimes, white spots on leaves are not caused by pests, disease, or nutrient deficiencies but by environmental stress. Plants are highly sensitive to factors like light intensity, humidity, and airflow. Stress can cause bleaching, leaf spotting, or even stunted growth. By optimizing your plant’s environment and following consistent care routines, you can prevent these unsightly spots and maintain vibrant foliage.
Sunburn and Excessive Light
Excessive light or sudden exposure to direct sunlight can cause white spots on leaves, particularly for shade-loving or indoor plants. Sunburn damages leaf cells, leading to bleached patches that resemble fungal or mineral issues.
- Symptoms:
- White or pale spots on leaves facing windows or bright light sources.
- Edges may appear scorched or crispy.
- Prevention Tips:
- Gradually acclimate plants to higher light levels.
- Use sheer curtains or place plants in indirect sunlight.
- Rotate plants regularly so all leaves receive balanced exposure.
Expert insight: According to the Royal Horticultural Society (RHS), even common houseplants like philodendrons, pothos, and peace lilies can develop sunburn if moved abruptly to bright light. Gradual adaptation prevents white spots on leaves caused by light stress.
Humidity and Airflow Adjustments
Indoor environmental conditions can create stress that leads to white spots on leaves. Low humidity or stagnant air encourages leaf damage, while overly damp conditions can promote fungal infections.
- Humidity:
- Maintain 40–60% humidity for most tropical houseplants.
- Use humidifiers, pebble trays, or misting to increase moisture in dry rooms.
- Airflow:
- Ensure proper ventilation around plants to prevent heat or moisture stress.
- Avoid crowding multiple plants together, as it can reduce airflow and increase stress spots.
Case example: A gardener in Seattle observed ZZ plants with white spotting on older leaves. After introducing a small fan to improve airflow and placing a humidity tray nearby, new growth appeared vibrant, free of spots, and healthier overall.
General Plant Care Best Practices
Routine care habits play a significant role in preventing white spots on leaves from environmental stress:
- Consistent Watering: Water plants according to species needs, avoiding overwatering or letting soil dry out completely.
- Regular Cleaning: Wipe leaves to remove dust and debris, improving photosynthesis and reducing stress spots.
- Temperature Control: Keep plants in stable temperature ranges suitable for each species. Avoid placing them near heaters or drafty windows.
- Monitoring: Check leaves weekly for signs of stress, spotting, or discoloration. Early intervention prevents long-term damage.
Trustworthiness note: According to the University of Florida IFAS Extension, maintaining optimal environmental conditions—light, humidity, temperature, and airflow—is essential for healthy indoor plants and reduces the likelihood of white spots on leaves.
✅ Takeaway: Preventing environmental stress is a simple but often overlooked solution for white spots on leaves. By managing light exposure, humidity, airflow, and general care routines, you can ensure that your plants grow strong, resilient, and free of unsightly spots. Early attention and consistent care are the keys to maintaining healthy foliage.
How to Prevent White Spots on Leaves Altogether

Preventing white spots on leaves is always easier than treating them after they appear. By implementing a consistent preventive routine, monitoring plant health, and using proper care techniques, you can maintain lush, spot-free foliage. Prevention involves understanding the key stressors—pests, diseases, environmental factors, and mineral or nutrient imbalances—and addressing them proactively.
Step-by-Step Preventive Checklist
Follow these actionable steps to minimize the risk of white spots on leaves:
- Inspect plants weekly for early signs of pests or disease.
- Wipe leaves regularly to remove dust, mineral deposits, and potential fungal spores.
- Quarantine new plants for 1–2 weeks before introducing them to your collection.
- Rotate plants to ensure even light exposure and prevent sunburn or stress spots.
- Test soil periodically to monitor nutrient levels, particularly calcium and magnesium.
Expert insight: According to the University of California Integrated Pest Management Program, regular inspection and early intervention are the most effective ways to prevent leaf spotting and other plant health issues.
Cleaning Tools, Spacing Plants, and Monitoring Regularly
Proper hygiene and spacing can greatly reduce the risk of white spots on leaves:
- Cleaning Tools:
- Sterilize pruners, scissors, and pots to prevent cross-contamination of pests or pathogens.
- Plant Spacing:
- Avoid overcrowding; adequate spacing improves airflow, reducing fungal growth and stress-related spots.
- Regular Monitoring:
- Check leaves for early discoloration or residue buildup.
- Inspect both the tops and undersides of leaves, as pests like spider mites are often hidden.
Case study: A houseplant collector in New York noticed recurring white spotting on her indoor ferns. After spacing plants further apart, improving airflow with a small fan, and wiping leaves weekly, the problem did not recur. New fronds emerged healthy and free of white spots on leaves.
Recommended Care Routine (Weekly Inspection, Proper Watering)
A structured weekly care routine helps prevent the common causes of white spots on leaves:
- Inspection: Examine leaves, stems, and soil for signs of pests, disease, or nutrient deficiencies.
- Watering Practices: Water consistently at the soil level to avoid mineral buildup or leaf stress. Use distilled or filtered water when necessary.
- Humidity and Environment: Maintain appropriate humidity levels for tropical plants, and ensure moderate light exposure.
- Fertilization: Apply balanced fertilizers in recommended doses to prevent deficiencies that can lead to spotting.
Authority note: The Royal Horticultural Society (RHS) emphasizes that a proactive care routine not only prevents white spots on leaves but also enhances overall plant vitality and longevity.
✅ Takeaway: Preventing white spots on leaves involves a combination of early detection, proper spacing, clean tools, consistent monitoring, and a structured care routine. By following these preventive measures, you ensure your plants remain healthy, vibrant, and free from unsightly spots, saving time and effort compared to reactive treatments.
FAQ – White Spots on Leaves
What causes white spots on leaves?
White spots on leaves are commonly caused by fungal infections, pests like spider mites or mealybugs, mineral buildup from hard water, or environmental stress such as sunburn. Identifying the cause early ensures you can treat your plants effectively and prevent further damage.
How can I get rid of white spots on leaves?
To remove white spots on leaves, first determine the cause. Treat fungal infections with neem oil or fungicides, remove pests using insecticidal soap, wipe off mineral residue with distilled water, and adjust environmental conditions like light, humidity, and airflow to prevent recurrence.
Why do some houseplants develop white spots on leaves?
Houseplants may develop white spots on leaves due to poor watering practices, nutrient deficiencies, excessive sunlight, or low humidity. Common offenders include calcium or magnesium deficiency, hard water, or pests that feed on plant sap, causing visible spotting on foliage.
When should I worry about white spots on leaves?
You should be concerned if white spots on leaves spread quickly, appear with yellowing, wilting, or sticky residue. Rapid progression can indicate pests, fungal disease, or nutrient issues that require prompt intervention to protect overall plant health.
Can I prevent white spots on leaves?
Yes. Prevent white spots on leaves by maintaining proper watering, using filtered or distilled water, ensuring adequate light and humidity, regularly inspecting plants for pests, and applying balanced fertilizers to prevent nutrient deficiencies. Consistent care keeps foliage healthy and spot-free.
What is the difference between fungal white spots and mineral residue?
Fungal white spots on leaves are often powdery, irregular, and may spread quickly, while mineral residue appears as chalky, uniform deposits that can usually be wiped off. Correctly identifying the cause ensures you choose the proper treatment for healthy, clean foliage.
Dealing with white spots on leaves doesn’t have to be overwhelming. By identifying the cause—whether fungal infections, pests, mineral buildup, or stress—you can apply quick fixes and restore your plant’s health. With consistent care and preventive practices, your greenery will stay vibrant and spot-free. 🌱 Want more plant care tips and expert advice? Subscribe to our newsletter and explore our latest guides to keep your plants thriving all year long.








2 Comments